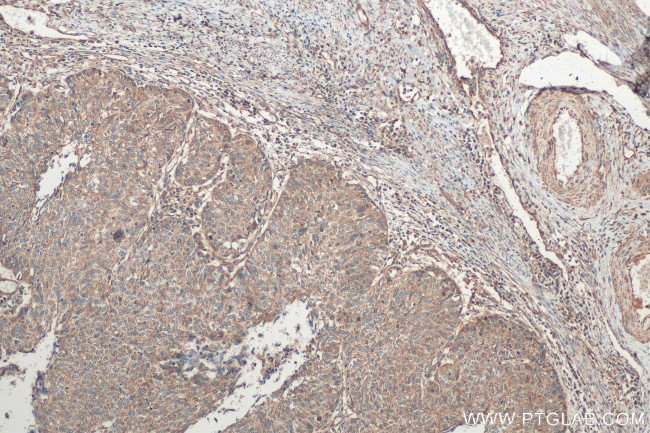
STC1 Antibody in Immunohistochemistry (Paraffin) (IHC (P))

Search
Proteintech
STC1 Polyclonal Antibody
{{$productOrderCtrl.translations['antibody.pdp.commerceCard.promotion.promotions']}}
{{$productOrderCtrl.translations['antibody.pdp.commerceCard.promotion.viewpromo']}}
{{$productOrderCtrl.translations['antibody.pdp.commerceCard.promotion.promocode']}}: {{promo.promoCode}} {{promo.promoTitle}} {{promo.promoDescription}}. {{$productOrderCtrl.translations['antibody.pdp.commerceCard.promotion.learnmore']}}
产品信息
20621-1-AP
种属反应
宿主/亚型
分类
类型
抗原
偶联物
形式
浓度
规格
纯化类型
保存液
内含物
保存条件
运输条件
产品详细信息
Immunogen sequence: CIANGVTSK VFLAIRRCST FQRMIAEVQE ECYSKLNVCS IAKRNPEAIT EVVQLPNHFS NRYYNRLVRS LLECDEDTVS TIRDSLMEKI GPNMASLFHI LQTDHCAQTH PRADFNRRRT NEPQKLKVLL RNLRGEEDSP SHIKRTSHES A (98-247 aa encoded by BC029044)
靶标信息
This gene encodes a secreted, homodimeric glycoprotein that is expressed in a wide variety of tissues and may have autocrine or paracrine functions. The gene contains a 5' UTR rich in CAG trinucleotide repeats. The encoded protein contains 11 conserved cysteine residues and is phosphorylated by protein kinase C exclusively on its serine residues. The protein may play a role in the regulation of renal and intestinal calcium and phosphate transport, cell metabolism, or cellular calcium/phosphate homeostasis. Overexpression of human stanniocalcin 1 in mice produces high serum phosphate levels, dwarfism, and increased metabolic rate. This gene has altered expression in hepatocellular, ovarian, and breast cancers.
仅用于科研。不用于诊断过程。未经明确授权不得转售。
生物信息学
蛋白别名: Stanniocalcin-1; STC-1; unnamed protein product
基因别名: STC; STC1
UniProt ID: (Human) P52823, (Mouse) O55183, (Rat) P97574
Entrez Gene ID: (Human) 6781, (Mouse) 20855, (Rat) 81801